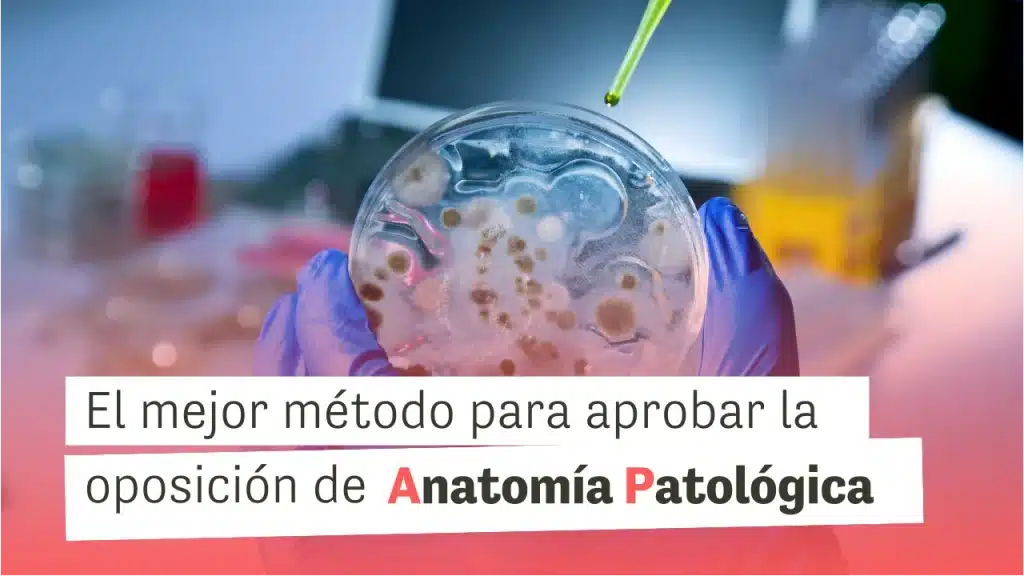
Oposiciones de Anatomía Patológica

Somos especialistas en oposiciones de Sanidad: contamos con preparadores expertos y plataforma especializada en Sanidad.
Preparamos Convocatorias en toda España, pregunta por tu Convocatoria y te informamos de todo. ¡No dejes pasar esta Oportunidad! ¡Alto porcentaje de aprobados!
Solicita información sin compromiso de: